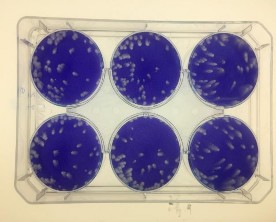
Thử nghiệm tạo đám hoại tử PFU trên tế bào BHK21 Thử nghiệm tạo đám 1
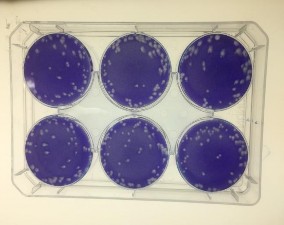
Thử nghiệm tạo đám hoại tử PFU trên tế bào BHK21 Thử nghiệm tạo đám 2

Trộn vắc xin của mỗi lọ sau khi cân được lại, đo tỷ trọng.
Khối lượng vắc xin trong từng lọ
Thể tích đóng lọ =
Kiểm tra Mycoplasma
Tỷ trọng vắc xin
Mycoplasma là một trong các tác nhân có nguy cơ tạp nhiễm trong quá trình sản xuất chủng. Trong nghiên cứu này kiểm tra Mycoplasma được thực hiện để kiểm tra chất lượng chủng Beijing-1 sau sản xuất.
Phương pháp sử dụng là nuôi cấy trực tiếp: Cấy trực tiếp mẫu vào môi trường thạch PPLO (pleuropneumonia-like organism agar, là môi trường chuyên dụng cho nuôi cấy và phát hiện Mycoplasma), ủ ở 370C/21 ngày.
Quy trình thực hiện cụ thể: theo hướng dẫn của DĐVN V, 2017, PL 15.47: “Kiểm tra Mycoplasma trong vắc xin/sinh phẩm”.
2.6. Xử lý và phân tích số liệu
Kết quả thử nghiệm của chủng và vắc xin được ghi chép theo các biểu mẫu tiêu chuẩn của VABIOTECH và NICVB. Số liệu thí nghiệm vắc xin được ghi chép, nhập và xử lý bằng phần mềm Excel.
Các phân tích mô tả được sử dụng để mô tả các giá trị trung bình về trọng lượng và phần trăm tăng trọng lượng của chuột lang, chuột nhắt thí nghiệm; mức tăng nhiệt độ của thỏ thí nghiệm; công hiệu, pH, hàm lượng protein tổng số của các loạt vắc xin thử nghiệm.
Kết quả số liệu phân tích được trình bày dưới dạng các bảng thống kê số liệu.
CHƯƠNG 3
KẾT QUẢ VÀ BÀN LUẬN
3.1. Kết quả nghiên cứu
3.1.1. Tính ổn định về hiệu giá và di truyền của chủng Beijing-1
3.1.1.1. Thử nghiệm nhận dạng trên ngân hàng chủng gốc và chủng sản xuất
Bảng 3.1. Kết quả nhận dạng của chủng gốc và chủng sản xuất bằng phương pháp ELISA
Kết quả OD trung bình | ||||
Blank/chứng âm | Mẫu chuẩn BR209 | BV-MSV-0210 | BV-WSV-0310 | |
10 | 0,008 | 0,65 | 1,62 | 1,64 |
40 | 0,007 | 0,205 | 0,961 | 1,02 |
160 | 0,007 | 0,073 | 0,52 | 0,44 |
640 | 0,008 | 0,042 | 0,14 | 0,18 |
Có thể bạn quan tâm!
-
Tóm Tắt Quy Trình Thiết Lập Ngân Hàng Chủng (Beijing-1) Để Sản Xuất Vắc Xin Viêm Não Nhật Bản Bất Hoạt Trên Tế Bào Vero Tại Việt Nam -
Trang Thiết Bị, Vật Tư Tiêu Hao Sử Dụng Trong Nghiên Cứu -
Thông Tin Về Trình Tự Vùng Gen E Của Các Chủng Vi Rút Vnnb Phân Lập Ở Việt Nam Trong Các Năm Khác Nhau Và Từ Các Vật Chủ Khác Nhau Sử Dụng Trong -
Tính Ổn Định Hiệu Giá Chủng Gốcbv-Msv-0210 Và Chủng Sản Xuất Bv- Wsv-0310 Khi Bảo Quản Trong Nitrogen Lỏng -
Kết Quả Đánh Giá Cảm Quan, Tỷ Trọng Và Vô Trùng Của 10 Lô Vắc Xin Jecevax -
Sự Tương Đồng Kháng Nguyên Của Chủng Sản Xuất Vắc Xin Vnnb So Với Các Chủng Viêm Não Nhật Bản Lưu Hành Tại Việt Nam
Xem toàn bộ 178 trang tài liệu này.
Kết quả nhận dạng chủng gốc (BV-MSV-0210) và chủng sản xuất (BV-WSV- 0310) bằng phương pháp ELISA cho thấy, ở nồng độ pha loãng 640 lần, OD của chủng gốc cao hơn khoảng 17,5 lần so với mẫu Blank/chứng âm và chủng sản xuất cao hơn khoảng 22,5 lần so với mẫu Blank/chứng âm. Kết quả này chứng tỏ rằng chủng gốc và chủng sản xuất có hàm lượng kháng nguyên rất cao. Tại độ pha loãng 10 lần, chủng gốc và chủng sản xuất đều có hàm lượng kháng nguyên cao hơn mẫu chuẩn gấp khoảng 2,5 lần (bảng 3.1).
Kết quả giải trình tự gen của vi rút của chủng gốc (BV-MSV-0210) và chủng sản xuất (BV-WSV-0310) cho thấy trình tự nucleotide và trình tự axit amin vùng gen sinh tổng hợp kháng nguyên E của 2 chủng này có sự tương đồng 100% và so với chủng chuẩn tham chiếu Reference JEV Beijing-Kanonji cũng tương đồng 100% (Hình 3.1).
A
B
Hình 3. 1. Kết quả giải trình tự gen và xây dựng cây phả hệ dựa trên trình tự nucleotide (A) và axít amin (B) của chủng gốc và chủng sản xuất với chủng Beijing chuẩn
3.1.1.2. Kết quả kiểm tra hiệu giá vi rút chủng gốc và chủng sản xuất
Bảng 3.2. Kết quả kiểm tra LD50 trên não chuột Swiss của chủng gốc BV-MSV- 0210
Số chuột thí nghiệm | Số chuột sống | Số chuột chết | % chuột chết | Hiệu giá chủng (LD50) | |
10-6 | 10 | 0 | 10 | 100 | 4,79.107 |
10-7 | 10 | 2 | 8 | 85,7 | |
10-8 | 10 | 6 | 4 | 33,33 |
Kết quả kiểm tra hiệu giá vi rút trên não chuột của chủng gốc (BV-MSV- 0210), ở độ pha 10-6 chuột chết 100%, độ pha 10-7 tỷ lệ chết 85,7% (>50%), độ pha 10-8 tỷ lệ chết 33,33 %(<50%). LD50 của chủng xác định là 4,79.107. Hiệu giá của chủng gốc được xác định là > 107/ml, đạt tiêu chuẩn dự kiến là ≥ 107/ml (bảng 3.2).
Bảng 3. 3. Kết quả kiểm tra LD50trên não chuột Swiss của chủng sản xuất BV- WSV-0310
Số chuột thí nghiệm | Số chuột sống | Số chuột chết | % chuột chết | Hiệu giá chủng (LD50) | |
10-6 | 10 | 0 | 10 | 100 | 2,24.107 |
10-7 | 10 | 3 | 7 | 72,7 | |
10-8 | 10 | 9 | 1 | 7,7 |
Kết quả kiểm tra hiệu giá vi rút trên não chuột của chủng sản xuất(BV-WSV- 0310) cho thấy, ở độ pha 10-6 chuột chết 100%, độ pha 10-7 tỷ lệ chết 72,7% (>50%), độ pha 10-8 tỷ lệ chết 7,7 %(<50%). LD50 của chủng xác định là 2,24.107. Hiệu giá của chủng sản xuất được xác định là > 107/ml, đạt tiêu chuẩn dự kiến là ≥ 107/ml (bảng 3.3).
Hiệu giá chủng vi rút sản xuất vắc xin Viêm não Nhật Bản BV-WSV-0310 được thực hiện bằng phương pháp tạo đám hoại tử PFU/ml trên tế bào sau 5 ngày gây nhiễm được mô tả tại hình 3.2.
10-8
10-6
10-7
Hình 3.2. Hình ảnh plaque (đám hoại tử- đốm trắng) của chủng sản xuất BV-WSV- 0310 ở các độ pha 10-6; 10-7; 10-8
Bảng 3.4. Kết quả kiểm tra hiệu giá chủng gốc BV-MSV-0210bằng thử nghiệm tạo đám hoại tử (PFU) trên tế bào BHK21
Số plaque | Hiệu giá (PFU/ml) | Hiệu giá trung bình (PFU/ml) | ||
Số plaque | Trung bình | |||
10-5 | 100; 137 | 118,5 | 5,92.107 | 8,72.107 (hay 7,94 log) |
10-6 | 22; 19 | 20,5 | 10,25.107 | |
10-7 | 1; 3 | 2,0 | 10,00.107 | |
10-8 | 0;0 | 0 | 0 |
Bằng phương pháp thử nghiệm trên tế bào, hiệu giá trung bình của chủng gốc BV-MSV-0210 là 8,72x107 PFU/ml (bảng 3.4).
Bảng 3.5. Kết quả kiểm tra hiệu giá chủng sản xuất BV-WSV-0310 bằng thử nghiệm tạo đám hoại tử (PFU) trên tế bào BHK21
Số plaque | Hiệu giá (PFU/ml) | Hiệu giá trung bình (PFU/ml) | ||
Số plaque | Trung bình | |||
10-5 | 91;84 | 87,5 | 4,37. 107 | 3,93. 107 (hay 7,59 log) |
10-6 | 6;8 | 7 | 3,50.107 | |
10-7 | 0;0 | 0 | 0 |
Bằng phương pháp thử nghiệm trên tế bào, hiệu giá trung bình của chủng sản xuất BV-WSV-0310 là 3,93x107 PFU/ml (bảng 3.5).
Trước Vabiotech chỉ sử dụng tế bào BHK-21, trong nghiên cứu chúng tôi sử dụng thêm cả tế bào Vero là dòng tế bào sử dụng để sản xuất vắc xin để thẩm định sự phù hợp và cần thiết có thể thay thế tế bào BHK-21 cho tiện sử dụng kiểm định sau này.
| |
Thử nghiệm tạo đám hoại tử (PFU) trên tế bào BHK21 | Thử nghiệm tạo đám hoại tử (PFU) trên tế bào Vero |
Hình 3. 3.Hình ảnh plaque (đám hoại tử- đốm trắng) của chủng sản xuất BV-WSV- 0310 trên dòng tế bào BHK21 và dòng tế bào Vero.
Kết quả hình Plaque ở tế bào BHK21 tạo ra to hơn tế bào Vero nhưng số lượng (kết quả) như nhau và đều dễ đọc bằng mắt thường (hình 3.3).
3.1.1.3. Tính ổn định về di truyền của chủng theo thời gian cất giữ
a. Kết quả khuếch đại gen mã hóa kháng nguyên E của chủng gốc, chủng sản xuất và chủng tham chiếu
M
1
2
3
1500 bp-
1000 bp-
Hình 3. 4. Điện di gel agarose 1% kiểm tra sản phẩm RT-PCR khuếch đại gen mã hóa kháng nguyên E của các chủng: chủng gốc BV-MSV-0210 (đường chạy số 1); chủng sản xuất BV-WSV-0310 (đường chạy số 2); chủng chuẩn tham chiếu JEV Beijing-1 Kanonji (đường chạy số 3). M: Farmentas 1 kb DNA ladder.
Gen mã hóa kháng nguyên E của chủng gốc BV-MSV-0210 và chủng sản xuất BV-WSV-0310 so với chủng chuẩn tham chiếu JEV Beijing-Kanonji do Nhật Bản cung cấp đã được khuếch đại bằng RT-PCR. Kết quả cho thấy, sản phẩm PCR rất đặc hiệu, không có sản phẩm phụ, kích thước tương đương với độ dài của gen E theo tính toán lý thuyết (khoảng 1500 bp). Kết quả được nêu ở hình 3.4.
b. Kết quả giải trình tự và phân tích gen E của các chủng gốc và chủng sản xuất
ID SQ
BV-MSV-0210_P
PRELIMINARY; PRT; 500 AA.
SEQUENCE
500 AA; 53562 MW; 1331854 CN;
FNCLGMGNRD FIEGASGATW VDLVLEGDSC LTIMANDKPT LDVRMINIEA SQLAEVRSYC YHASVTDIST VARCPTTGEA HNEKRADSSY VCKQGFTDRG WGNGCGLFGK GSIDTCAKFS CTRKAIGRTI QPENIKYEVG IFVHGTTTSE NHGNYSAQVG ASQAAKFTVT PNAPSITLKL GDYGEVTLDC EPRSGLNTEA FYVMTVGSKS FLVHREWFHD LALPWTPPSS TAWRNRELLM EFEEAHATKQ SVVALGSQEG GLHQALAGAI VVEYSSSVKL TSGHLKCRLK MDKLALKGTT YGMCTEKFSF AKNPADTGHG TVVIELSYSG SDGPCKIPIV SVASLNDMTP VGRLVTVNPF VATSSANSKV LVEMEPPFGD SYIVVGRGDK QINHHWYKAG STLGKAFSTT LKGAQRLAAL GDTAWDFGSI GGVFNSIGKA VHQVFGGAFR TLFGGMSWIT QGLMGALLLW MGINARDRSI ALAFLATGGV LVFLATNVHA
A
//
ID SQ
BV-WSV-0310_P
PRELIMINARY; PRT; 500 AA.
SEQUENCE
500 AA; 53562 MW; 1331854 CN;
FNCLGMGNRD FIEGASGATW VDLVLEGDSC LTIMANDKPT LDVRMINIEA SQLAEVRSYC YHASVTDIST VARCPTTGEA HNEKRADSSY VCKQGFTDRG WGNGCGLFGK GSIDTCAKFS CTRKAIGRTI QPENIKYEVG IFVHGTTTSE NHGNYSAQVG ASQAAKFTVT PNAPSITLKL GDYGEVTLDC EPRSGLNTEA FYVMTVGSKS FLVHREWFHD LALPWTPPSS TAWRNRELLM EFEEAHATKQ SVVALGSQEG GLHQALAGAI VVEYSSSVKL TSGHLKCRLK MDKLALKGTT YGMCTEKFSF AKNPADTGHG TVVIELSYSG SDGPCKIPIV SVASLNDMTP VGRLVTVNPF VATSSANSKV LVEMEPPFGD SYIVVGRGDK QINHHWYKAG STLGKAFSTT LKGAQRLAAL GDTAWDFGSI GGVFNSIGKA VHQVFGGAFR TLFGGMSWIT QGLMGALLLW MGINARDRSI ALAFLATGGV LVFLATNVHA
B
Hình 3. 5. Trình tự acid amin kháng nguyên E của vi rút VNNB lô chủng giống gốc BV-MSV-0210 (A) và sản xuất BV-WSV-0310 (B)
ID SQ
BV-MSV-0210
PRELIMINARY; DNA; 1500 BP.
SEQUENCE
1500 BP;
393 A;
362 C; 411 G;
334 T;
TTCAACTGTC TGGGAATGGG CAATCGTGAC TTCATAGAAG GAGCCAGTGG AGCCACTTGG GTGGACTTGG TGCTAGAAGG AGACAGCTGC TTGACAATCA TGGCAAACGA CAAACCAACA TTGGACGTCC GCATGATCAA CATCGAAGCT AGCCAACTTG CTGAGGTCAG AAGTTACTGC TATCATGCTT CAGTCACTGA CATCTCGACG GTGGCTCGGT GCCCCACGAC TGGAGAAGCC CACAACGAGA AGCGAGCTGA TAGTAGCTAT GTGTGCAAAC AAGGCTTCAC TGATCGTGGG TGGGGCAACG GATGTGGACT TTTCGGGAAG GGAAGTATTG ACACATGTGC AAAATTCTCC TGCACCAGGA AAGCGATTGG GAGAACAATC CAGCCAGAAA ACATCAAATA CGAAGTTGGC ATTTTTGTGC ATGGAACCAC CACTTCGGAA AACCATGGGA ATTATTCAGC GCAAGTTGGG GCGTCCCAGG CGGCAAAGTT TACAGTAACA CCTAATGCTC CTTCGATAAC CCTCAAACTT GGTGACTACG GAGAAGTCAC ACTGGACTGT GAGCCAAGGA GTGGACTAAA CACTGAAGCG TTTTACGTCA TGACCGTGGG GTCAAAGTCA TTTTTGGTCC ATAGGGAATG GTTTCATGAC CTCGCTCTCC CTTGGACGCC CCCTTCGAGC ACAGCGTGGA GAAACAGAGA ACTCCTCATG GAATTTGAAG AGGCGCACGC CACAAAACAG TCCGTTGTTG CTCTTGGGTC ACAGGAAGGA GGCCTCCATC AGGCGTTGGC AGGAGCCATC GTGGTGGAGT ACTCAAGCTC AGTGAAGTTA ACATCAGGCC ACCTAAAATG CAGGCTGAAA ATGGACAAAC TGGCTCTGAA AGGCACAACC TATGGTATGT GCACAGAAAA ATTCTCGTTC GCGAAAAATC CGGCGGACAC TGGTCACGGA ACAGTTGTCA TTGAACTTTC ATACTCTGGG AGTGATGGCC CCTGCAAGAT TCCGATTGTC TCCGTTGCTA GCCTCAATGA CATGACCCCC GTCGGGCGGC TGGTGACAGT GAACCCCTTC GTCGCGACTT CCAGCGCCAA CTCAAAGGTG CTGGTCGAGA TGGAACCCCC CTTCGGAGAC TCCTACATCG TAGTTGGAAG GGGAGACAAG CAGATTAACC ACCATTGGTA CAAGGCTGGA AGCACGCTGG GCAAAGCCTT TTCAACGACT TTGAAGGGAG CTCAAAGACT GGCAGCGTTG GGCGACACAG CCTGGGACTT TGGCTCTATT GGAGGGGTCT TCAACTCCAT AGGGAAAGCT GTTCACCAAG TGTTTGGTGG TGCCTTCAGA ACACTCTTTG GGGGAATGTC TTGGATCACA CAAGGGCTAA TGGGGGCCCT ACTACTTTGG ATGGGCATCA ACGCACGAGA CCGATCAATT GCTTTGGCCT TCTTAGCCAC AGGAGGTGTG CTCGTGTTCT TAGCTACCAA TGTGCATGCT
A
//
ID
SQ
BV-WSV-0310_N
PRELIMINARY; ADN; 1500 BP.
SEQUENCE
1500 BP;
393 A;
362 C;
411 G;
334 T;
TTCAACTGTC TGGGAATGGG CAATCGTGAC TTCATAGAAG GAGCCAGTGG AGCCACTTGG GTGGACTTGG TGCTAGAAGG AGACAGCTGC TTGACAATCA TGGCAAACGA CAAACCAACA TTGGACGTCC GCATGATCAA CATCGAAGCT AGCCAACTTG CTGAGGTCAG AAGTTACTGC TATCATGCTT CAGTCACTGA CATCTCGACG GTGGCTCGGT GCCCCACGAC TGGAGAAGCC CACAACGAGA AGCGAGCTGA TAGTAGCTAT GTGTGCAAAC AAGGCTTCAC TGATCGTGGG TGGGGCAACG GATGTGGACT TTTCGGGAAG GGAAGTATTG ACACATGTGC AAAATTCTCC TGCACCAGGA AAGCGATTGG GAGAACAATC CAGCCAGAAA ACATCAAATA CGAAGTTGGC ATTTTTGTGC ATGGAACCAC CACTTCGGAA AACCATGGGA ATTATTCAGC GCAAGTTGGG GCGTCCCAGG CGGCAAAGTT TACAGTAACA CCTAATGCTC CTTCGATAAC CCTCAAACTT GGTGACTACG GAGAAGTCAC ACTGGACTGT GAGCCAAGGA GTGGACTAAA CACTGAAGCG TTTTACGTCA TGACCGTGGG GTCAAAGTCA TTTTTGGTCC ATAGGGAATG GTTTCATGAC CTCGCTCTCC CTTGGACGCC CCCTTCGAGC ACAGCGTGGA GAAACAGAGA ACTCCTCATG GAATTTGAAG AGGCGCACGC CACAAAACAG TCCGTTGTTG CTCTTGGGTC ACAGGAAGGA GGCCTCCATC AGGCGTTGGC AGGAGCCATC GTGGTGGAGT ACTCAAGCTC AGTGAAGTTA ACATCAGGCC ACCTAAAATG CAGGCTGAAA ATGGACAAAC TGGCTCTGAA AGGCACAACC TATGGTATGT GCACAGAAAA ATTCTCGTTC GCGAAAAATC CGGCGGACAC TGGTCACGGA ACAGTTGTCA TTGAACTTTC ATACTCTGGG AGTGATGGCC CCTGCAAGAT TCCGATTGTC TCCGTTGCTA GCCTCAATGA CATGACCCCC GTCGGGCGGC TGGTGACAGT GAACCCCTTC GTCGCGACTT CCAGCGCCAA CTCAAAGGTG CTGGTCGAGA TGGAACCCCC CTTCGGAGAC TCCTACATCG TAGTTGGAAG GGGAGACAAG CAGATTAACC ACCATTGGTA CAAGGCTGGA AGCACGCTGG GCAAAGCCTT TTCAACGACT TTGAAGGGAG CTCAAAGACT GGCAGCGTTG GGCGACACAG CCTGGGACTT TGGCTCTATT GGAGGGGTCT TCAACTCCAT AGGGAAAGCT GTTCACCAAG TGTTTGGTGG TGCCTTCAGA ACACTCTTTG GGGGAATGTC TTGGATCACA CAAGGGCTAA TGGGGGCCCT ACTACTTTGG ATGGGCATCA ACGCACGAGA CCGATCAATT GCTTTGGCCT TCTTAGCCAC AGGAGGTGTG CTCGTGTTCT TAGCTACCAA TGTGCATGCT
B
//
Hình 3. 6. Trình tự nucleotide gen mã hóa kháng nguyên E của vi rút VNNB lô chủng giống gốc BV-MSV-0210 (A) và lô chủng sản xuất BV-WSV-0310 (B)m